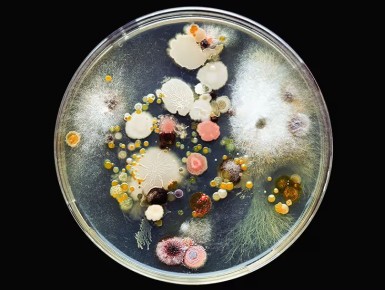
Почва как живой организм: как защитить себя от опасных инфекций

Сегодня — Старый Новый год!
До 1918 года Россия жила по юлианскому календарю («старому стилю») и праздновала Новый год позже Европы. После перехода на современный григорианский календарь дата сместилась на 13 дней вперёд. Но народная любовь к празднику оказалась сильнее: традиция встречать Новый год по-старому сохранилась.
Говорят, как встретишь этот день — таким и будет весь год. Поэтому самый верный рецепт — провести его осознанно, с удовольствием и в кругу самых близких.
Поздравляем вас со Старым Новым годом! Пусть в вашем доме всегда царят уют, сердечное тепло и взаимопонимание.
А чтобы ваши поздравления стали ещё душевнее, мы подготовили для вас открытки с узнаваемыми уголками Югры. Отправьте их родным и друзьям, чтобы разделить радость этого тёплого, семейного праздника!